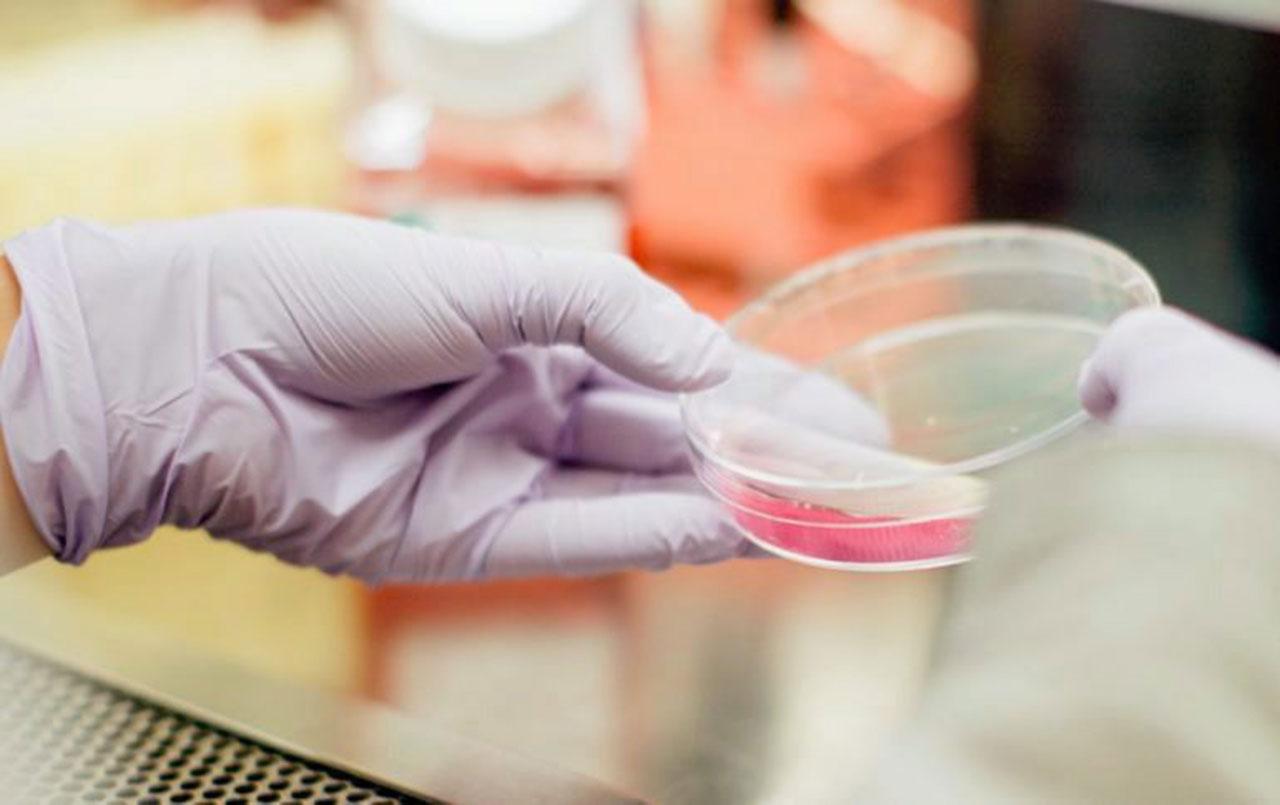

ในช่วงเวลาไม่กี่ปีนี้มีคนไข้เป็นจำนวนมากที่มีอาการเดินติดพื้น เดินลำบาก ปัสสาวะ กลั้นไม่อยู่ พร้อมกับเริ่มมีหรือมีความผิดปกติชัดเจนทางความทรงจำ การตัดสินใจแม้กระทั่งถึงมีความผิดปกติในด้านการสื่อสารทางภาษา การช่วยตนเองในกิจวัตรประจำวัน
คนไข้เหล่านี้ได้รับการผ่าตัดระบายน้ำในช่องโพรงสมองลงมาที่ช่องท้อง เพื่อที่จะบรรเทาอาการที่เรียกว่า “น้ำคั่ง” แม้ว่าจะมีอาการดีขึ้น แต่มีผู้ป่วยจำนวนหนึ่งที่มีอาการเลวลงจนกระทั่งถึงติดเตียง และในจำนวนนั้น ภาวะสมองเสื่อมซึ่งดูไม่มากกลับพัฒนามากขึ้น และอีกจำนวนหนึ่งมีอาการเท่าเดิม
สิ่งที่ต้องทราบก็คือการที่มีโพรงสมองที่บรรจุน้ำอยู่มีขนาดใหญ่ขึ้น โดยไม่มีอาการปวดหัว ใดๆ ภาวะดังกล่าวอาจเกิดเนื่องจาก การที่เนื้อสมองมีการฝ่อตัวลง จึงทำให้โพรงน้ำในสมองมีขนาด ใหญ่ขึ้น และภาวะนี้ไม่ใช่น้ำคั่ง ในสมองจริง และการผ่าตัดไม่เกิดประโยชน์แน่นอนแต่เพิ่มอันตรายจากการผ่าตัดและการดมยาในผู้ป่วยเหล่านี้

โดยที่ต้องไม่ลืมว่าการดมยาสลบเป็นเรื่องที่ทราบ ไม่ว่าจะเป็นการศึกษาในคนป่วยในซีกโลก ตะวันตกหรือในผู้ป่วยเอเชียก็ตาม จะมีผลทำให้มีอาการทางสมองปรากฏตัวขึ้นเร็ว โดยที่อธิบายว่าผู้ป่วยเหล่านี้มีโปรตีนบิดตัว (misfolded protein) สะสมกระจุกตัวอยู่แล้ว แม้อาการภายนอกจะไม่มีหรือแทบไม่มีก็ตาม กลับมีการสร้างสะสมลุกลามมากขึ้นจนกระทั่งทำให้การทำงานของสมองผิดปกติไปอย่างเห็นได้ชัดในเวลาอันรวดเร็ว
...
การที่มีน้ำคั่งในสมองจริงนั้น สามารถยืนยันได้จากการวัดความดันในสมองเป็นระยะหรือต่อเนื่องโดยปรากฏมีความดันขึ้นเป็นพักๆ และร่วมด้วยกับการเจาะระบายน้ำ ไขสันหลังและผู้ป่วยมีอาการดีขึ้น เช่น การเดิน หรือการกลั้นปัสสาวะไม่อยู่ สำหรับการตรวจดูรูระบายน้ำที่ก้านสมองส่วนบนว่าน้ำไม่ค่อยเคลื่อนไหว แสดงว่ามีการคั่งของน้ำ อาจจะไม่ใช่ เป็นวิธีการที่แม่นยำนัก แม้กระทั่งการวัดขนาดและความโค้งของช่องโพรงสมอง ว่าควรจะเป็นกระบวนการน้ำคั่งก็ตาม
กลุ่มผู้ป่วยที่การตรวจพบว่าน่าจะ มีน้ำค้างคั่งจริง โดยเริ่มมีรายงานตั้งแต่ปี 2010 ในวารสารของสมาคมสมองของสหรัฐฯ (annals of Neurology) โดยสรุปว่าการผ่าตัดระบายน้ำจะไม่ได้ผลเลยในกลุ่มที่มีเชื้อหรือที่เรียกว่าโปรตีนบิดตัว อัลไซเมอร์ รายงานในปี 2010 นี้มีจุดประสงค์เพื่อที่จะสร้างความกระจ่างในข้อสงสัยที่ว่าการระบายน้ำสามารถ ช่วยให้ผู้ป่วยดีขึ้นได้จริงหรือไม่ แม้ว่าในสมองผู้ป่วยจะมีลักษณะของอัลไซเมอร์ ได้แก่ การกระจุกตัวของอมิลอยด์ เบต้า (amyloid beta plaque) และโปรตีนเทา (tau neurofibrillary tangle)
ในผู้ป่วย 37 รายที่ได้รับการผ่าตัดระบายน้ำในสมองและพร้อมกันนั้นก็ได้มีการตัดชิ้นเนื้อบริเวณผิวสมอง เพื่อดูว่ามีลักษณะของอัลไซเมอร์ มากน้อยหรือไม่ ผู้ป่วยทั้งหมดจะได้รับการประเมิน การเคลื่อนไหว การทรงตัวและการทำงานของพุทธิปัญญาหรือกระบวนการทำงานของสมอง
ในผู้ป่วย 37 รายนี้ 25 รายมีลักษณะความผิดปกติของเนื้อสมองร่วมอยู่ด้วย และถ้ามีความผิดปกติมาก ผลของการผ่าตัดจะไม่ค่อยดีนักเมื่อเทียบกับกลุ่มที่มีความผิดปกติน้อยและกลุ่มที่ไม่ผิดปกติเลยเมื่อทำการติดตามไปเป็นระยะเวลาสี่เดือน ถึงแม้จะมีข้อจำกัดในการศึกษาในรายงานนี้ แต่เริ่มเป็นการเตือนให้มีการพิจารณาผู้ป่วยให้ดีก่อนจะทำการผ่าตัดระบายน้ำ โดยเฉพาะผู้ป่วยที่มี อาการทางสมองที่สามารถตรวจได้หรือสามารถเห็นได้จากอาการอยู่แล้ว
รายงานฉบับที่สองอยู่ในวารสารเดียวกัน ในปี 2017 โดยคณะผู้รายงานได้ทำการรวบรวมและวิเคราะห์วิธีการวินิจฉัยภาวะน้ำคั่งในสมอง ด้วยกระบวนการต่างๆ จากรายงานก่อนหน้าทั้งหมด โดยแสดงว่า ไม่สามารถจะชี้ชัดได้ว่าการระบายน้ำที่ได้ผลดีนั้นจะขึ้นอยู่กับอะไรบ้าง
แต่ข้อสรุปที่ชัดเจนที่สุดอยู่ที่การที่ผู้ป่วยมีความผิดปกติของเนื้อสมองร่วมอยู่ด้วยตั้งแต่ต้นหรือไม่ ไม่ว่าจะเป็นสมองเสื่อมชนิดอัลไซเมอร์ ชนิด Lewy bodies และชนิด progressive supranuclear palsy ก็ตาม จะมีผลลัพธ์จากการผ่าตัดที่ไม่ดีหรือดีได้แต่เป็นในระยะสั้น และเลวลงอีก ทั้งนี้ ได้จากการรวบรวมผู้ป่วยที่มหาวิทยาลัยซินซินเนติ ของประเทศสหรัฐฯเป็นเวลา 10 ปี
ในผู้ป่วยจำนวน 142 รายที่ส่งมายังโรงพยาบาลด้วยลักษณะอาการเข้ากันได้กับน้ำคั่งในสมอง มี 49 รายที่ไม่เข้ากับไม่ได้เป็นภาวะนี้จริง และอีก 62 รายที่ได้ลองระบายน้ำจากช่องโพรงไขสันหลัง (โดยการเจาะน้ำไขสันหลังออก 50 ซีซี หรือในการค่อยๆระบายน้ำอย่างช้าๆ 10 ซีซีต่อชั่วโมงต่อวันเป็นเวลาสามวัน) และไม่ดีขึ้น ทั้งสองกลุ่มนี้ได้ถูกตัดออก
จำนวนที่เหลือ 31 รายได้รับการผ่าตัดระบายน้ำในสมอง มี 10 รายที่มีอาการยังคงดีขึ้นหลังจาก 36 เดือนไปแล้ว ในขณะที่ 11 รายหลังจาก 12 เดือนกลับเลวลง 6 รายหลังจาก 24 เดือน และ 4 รายหลังจาก 36 เดือนกลับเลวลง ในจำนวน 21 รายนี้ 8 รายมีการวินิจฉัยสุดท้ายว่า มีสมองเสื่อมชนิด Lewy bodies 3 ราย อัลไซ-เมอร์ 2 progressive Supranuclear palsy 2 และเป็นสมองเสื่อมจากเส้นเลือดตันทั่วๆไปอีกหนึ่งราย
...

จากผลการรวบรวมวิเคราะห์และจากผลการติดตามของผู้ป่วยที่สถาบันนี้ ทำให้ได้ข้อสรุปโดย ไม่สามารถสรุปได้ว่าจะมีอะไรสามารถชี้ชัดว่าใครที่เป็นโรคน้ำคั่งในสมองจริง ซึ่งเมื่อผ่าตัดระบายน้ำไปแล้วสามารถที่จะคงสภาพอาการเดินให้ดีขึ้นได้ตลอดรอดฝั่งเกินสามปี และใครที่เป็นโรคน้ำคั่งในสมองจริงเมื่อได้รับการผ่าตัดไปแล้วจะไม่เลวลงไปอีก
กระบวนการที่จะประเมินโรคในเนื้อสมองที่จะเป็นตัวตัดสินว่า การผ่าตัดระบายน้ำจะได้ผลดีจริงตลอดรอดฝั่ง น่าจะต้องทำทั้งการตรวจลักษณะสายใยของเส้นประสาทที่เชื่อมโยงสมองส่วนต่างๆว่ามีความผิดปกติมากน้อยเพียงใดและอย่างไร เข้ากันได้กับน้ำคั่งอย่างเดียว หรือบ่งบอกว่ามีความผิดปกติของเนื้อสมองอย่างอื่นร่วม ทำการตรวจการสะสมของโปรตีนบิดเกลียวที่เป็นตัวการของโรคสมองเสื่อมแบบต่างๆ รวมกระทั่งถึงการดูว่าสมองส่วนใดไม่สามารถใช้พลังงานที่ได้จากกลูโคสได้ ซึ่งแสดงว่าสมองนั้นๆไม่ปกติแล้ว รวมถึงการตรวจเนื้อสมองขณะที่ทำการผ่าตัด หรือการวิเคราะห์สารที่บ่งชี้ถึงโรคสมองเสื่อมแบบต่างๆในน้ำไขสันหลัง เป็นต้น
แต่ไม่ว่าจะทำอย่างไรก็ตาม ในปัจจุบันนี้ สิ่งที่ต้องทำคือต้องบอกผู้ป่วยและครอบครัวของผู้ป่วยว่าแท้จริงแล้วอาจจะบอกไม่ได้ชัดเจนว่าการผ่าตัดจะทำให้ดีขึ้นได้หรือไม่และอาจเลวลงได้ และถึงแม้ว่าจะดีขึ้นน่าจะดีขึ้นในช่วงระยะเวลาเป็นเดือนเท่านั้น ก็ได้ นอกจากนั้นการวิเคราะห์ว่ามีน้ำคั่งใน สมองตั้งแต่ต้นต้องพิจารณาอย่างละเอียด รอบคอบโดยไม่ใช้การดูคอมพิวเตอร์สมองสนามแม่เหล็กไฟฟ้าแต่เพียงอย่างเดียว และ ในกรณีที่ผู้ป่วยมีอาการทางสมองเสื่อมชัดเจนอยู่แล้วผลที่ได้รับจากการผ่าตัดที่หวังว่าจะทำให้การเดินดีขึ้นอาจจะไม่ประสบผลสำเร็จนัก
...
ด้วยความเป็นห่วงครับ.
หมอดื้อ
